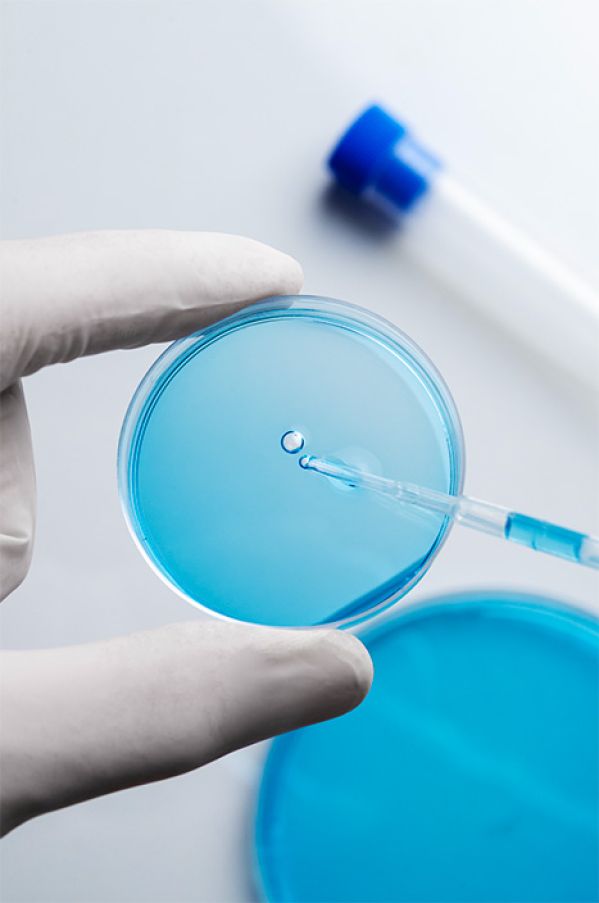

Digitalt værktøj, der fremmer sikker kemikaliehåndtering og understøtter universiteternes overholdelse af arbejdsmiljøregler.


Kemibrug er mere end blot en kemikaliedatabase. Vi er et konsortium formet ud fra et fælles mål og vision.

Din forskning

Dit studie

Din tryghed




En fusion af akademisk ekspertise
og praktisk anvendelse, som er
skabt gennem et samarbejde
mellem fire danske universiteter.

Samarbejdets mission og formål
Samarbejdets mission og formål DTU, KU, SDU og AAU har etableret et konsortium, der har en fælles mission om, at arbejdet omkring håndtering af kemikalier på universiteterne skal være sikkerheds- og sundhedsmæssigt forsvarligt for ansatte og studerende.
Konsortiets formål for at indfri missionen:
Sikre et grundlag for og understøttelse af universiteterne i at være lovmedholdelige på det kemiske område.
Understøtte risikovurderet arbejdsgang på universiteterne.
Minimere den administrative opgave for universiteterne ved håndtering af kemikalier.
Mindske ressourceforbruget på de enkelte universiteter.

FAQ
Ofte stillede spørgsmål
Kemibrug er et fælles It-system for Aalborg Universitet, Københavns Universitet, Syddansk Universitet og Danmarks Tekniske Universitet. Vi har siden 1988 udarbejdet brugsanvisninger på farlige stoffer og materialer der anvendes eller overvejes taget i brug. Brugsanvisningerne er understøttende skriftlige materiale til de lokale risikovurderinger
Ved uoverensstemmelse mellem leverandørs mærkning og CLP-reglerne retter Kemibrug henvendelse til leverandøren for udarbejdelse af et sikkerhedsdatablad, som er i overensstemmelse med Kemibrugs vurdering.
Kemibrug er en uvildig part og vi vurderer stofferne efter det data, som vi har adgang til. Leverandørerne vil til tider fastholde deres vurdering, hvilket vil give forskellen i mærkningen.
Stoffer med CAS nr. udarbejdes en fælles KBA, hvor vi kan hente information fra flere leverandører og finde den, som matcher Kemibrugs vurdering bedst.
Produkter udarbejdes ud fra en specifik SDS fra en navngiven leverandør, og i KBA’en henvises direkte til denne leverandør. Derfor kan der være flere KBA’er med den samme blanding, men med forskellig mærkning.
Nyhedsbrev
fra Kemibrug
Nyhedsbrevene indeholder information om nye initiativer, nyt om systemet etc.




